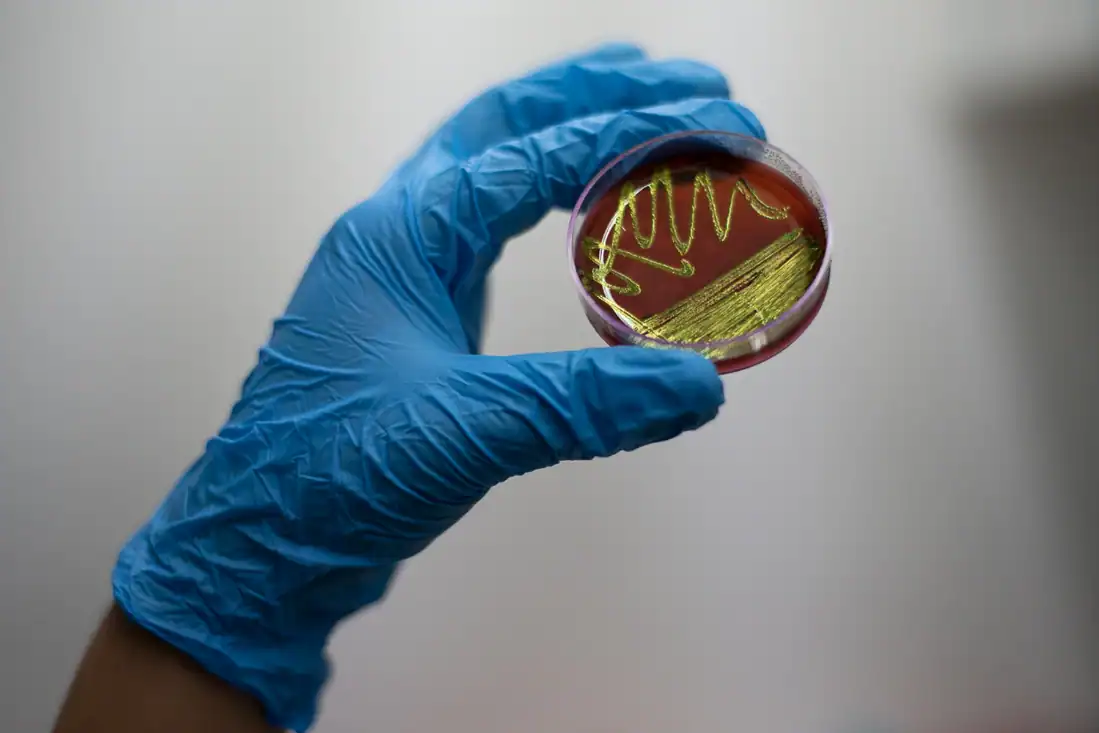
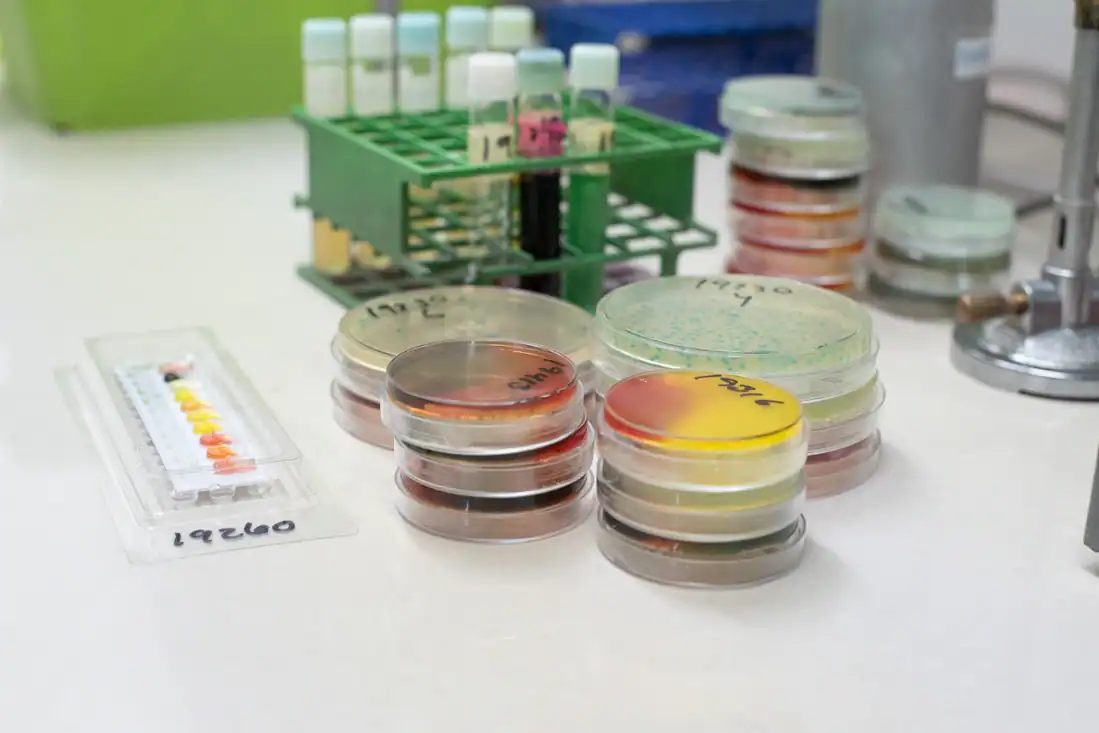

Construyendo
calidad

Liderazgo y confianza en laboratorios
Asegurar la calidad de los productos de nuestros clientes a través de asesoría experta, atención directa y resultados de laboratorio confiables.
Ser el laboratorio líder y de referencia en la región, reconocidos por nuestra mejora continua, la calidad en nuestra asesoría y el profesionalismo de nuestro equipo.
FQB Laboratorios se encuentra acreditado desde el año 2007, para mas información visita: orga.org.gt
Soluciones expertas en análisis
Con más de 35 años de experiencia , ofrecemos un portafolio completo de servicios diseñados para los sectores industrial y agrícola.
Compromiso, Calidad y Confianza

Nuestro Equipo de Expertos
Enterate de las últimas noticias
¿Esponjas o hisopos? El método más efectivo para detectar Listeria en superficies
¿Cuál método de muestreo es más efectivo para el monitoreo de L. monocytogenes en superficies: esponjas o hisopos? En el estudio realizado por Fornés ,…
0:45 min
0 comentarios
Consecuencias de la calidad de agua en vacunas para aves
Ensayo in vitro para evaluar el impacto de diferentes parámetros de calidad del agua en la estabilidad de una vacuna viva bivalente contra Salmonella (…
0:55 min
0 comentarios
Dispersión de alergenos en plantas de alimentos
Análisis de las características de dispersión de cinco polvos alimenticios para evitar el contacto cruzado involuntario con alérgenos alimentarios durante el procesamiento de alimentos En…
0:51 min
0 comentarios
¿Cómo entender mis reportes de laboratorio?
Listeria monocytogenes y Listeria sp
Un hallazgo de Listeria monocytogenes confirma la presencia de la cepa patógena específica que causa la listeriosis, una enfermedad grave y potencialmente mortal en humanos.…
6:43 min
0 comentarios
Aguas Residuales
Aguas residuales Los análisis se realizan de acuerdo a la regulación nacional con el AG 236-2006 donde los parámetros para determinar las características de las…
4:25 min
0 comentarios
Alérgenos
Los alérgenos en alimentos son proteínas presentes de forma natural en ciertos ingredientes quepueden provocar reacciones alérgicas en personas sensibles. Se reconocen varios ingredientes responsables…
2:8 min
0 comentarios